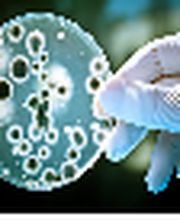
Sachverständigenbüro Produkt- und Betriebshygiene Logo

Sachverständigenbüro Produkt- und Betriebshygiene
Supermarkt
Info
Sachverständigenbüro für Produkt- und Betriebshygiene Prüfungen - Gutachten - Beratungen - Seminare. Hygieneschulungen und Hygienemanagement wie HACCP für Gastronomie und Catering, Großküchen. E-Learning Kurse zur schnellen Beschaffung von Weiterbildung mit Zertifikat. Hygienemanagement für Pflegedienstleistungen, für Arztpraxen und Kliniken. Qualität in der Hauswirtschaft und in Reinigungsunternehmen Qualitätsmanagement für Pflegeheime und Arztpraxen
Öffnungszeiten
- Montag
- 09:00 bis 17:00
- Dienstag
- 09:00 bis 17:00
- Mittwoch
- 09:00 bis 17:00
- Donnerstag
- 09:00 bis 17:00
- Freitag
- 09:00 bis 17:00
- Samstag
- Geschlossen
- Sonntag
- Geschlossen
Branchen / Spezialisierungen
SupermarktMedien
Map
Ostende 19, 22045 Hamburg
Bewertungen
Nicht verifizierte Bewertungen- Guest User
fachlich korrekt und dabei günstg


